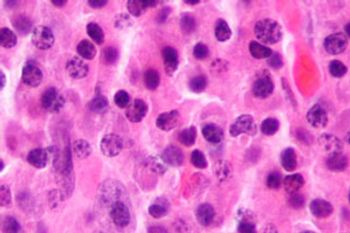

News


Jessie Desir, PhD, RN, AMB-BC, OCN, explained that comprehensive disease and treatment education are essential to adherence for patients with breast cancer.

Maintenance treatment with OSE2101 plus FOLFIRI following induction chemotherapy with FOLFIRINOX yielded promising results in patients with advanced/metastatic PDAC.

Seth Eisenberg, ASN, RN, OCN, BMTCN, explained his research on a toilet cover for oncology nurses to potentially reduce exposure to infectious pathogens and hazardous drugs.

Breast cancer survivors treated with endocrine therapy alone reported better long-term physical health outcomes compared with those who received chemotherapy.

Neoadjuvant and adjuvant durvalumab plus FLOT followed by durvalumab monotherapy improved EFS for patients with resectable gastric or GEJ cancer.

TLX007-CDx was approved by the FDA for PSMA-PET scanning in adult male patients with prostate cancer with suspected metastasis or suspected recurrence.

Oncology nurses and APPs provide support and can help to facilitate conversations with patients and families during end-of-life care.

Updated MAIA trial results reinforce the frontline benefit of daratumumab plus lenalidomide/dexamethasone in transplant-ineligible NDMM.

The FDA has approved treatment with pembrolizumab plus trastuzumab and chemotherapy for HER2+ gastric/GEJ adenocarcinoma with PD-L1 CPS of 1 or greater.

In myeloma treatment, acute CRS is a common but treatable AE associated with CAR T-cell therapy and bispecific antibodies, according to a nurse practitioner.

Alternating post-HCT care between specialized facilities and local cancer centers produced noninferior non-relapse mortality and similar quality of life to usual care.

Restaging cancer can be an unfamiliar space, but with more experience, APPs can rely less on MDs for guidance in such cases.

Cema-cel was associated with largely durable CRs in patients with CD19 CAR T-cell therapy-naïve relapsed/refractory LBCL.

While ambient particle levels differed by HEPA filter status, Splashblocker significantly reduced particles emitted from toilet plume aerosols regardless.

Working with multidisciplinary teams and educating patients are key to treating patients with cancer while navigating newly approved treatments.

The phase 3 COMPETE trial found that ITM-11 met its primary PFS end point and demonstrated a positive trend in OS for patients with GEP-NETs.

A phase 2 trial found that pembrolizumab plus pemetrexed met its objective response rate primary end point.

Working with interdisciplinary teams and nurse navigators to coordinate care across specialties is a facet of oncology nursing that may be overlooked, says an expert.

Palbociclib plus letrozole lengthened PFS vs placebo plus letrozole for patients with ER-positive advanced or recurrent endometrial cancer.

Patricia Jakel, MN, RN, AOCN, emphasized that the bond oncology nurses have with patients with cancer necessitates honest and often difficult conversations.

Two denosumab biosimilars have been approved by the FDA for all previously approved uses for the reference drugs in cancers and osteoporosis.

A recent study found that toxicity is routinely minimized in phase 3 oncology trials, especially those that are not industry sponsored.

Adding antihistamines to atezolizumab led to a 46% OS rate and a 23% PFS rate in metastatic urothelial carcinoma.

Panitumumab plus ipilimumab and nivolumab signaled complete or partial response in 18 patients with KRAS/NRAS/BRAF wild-type MSS mCRC at the 12-week mark.

Jessie Desir, PhD, RN, AMB-BC, OCN, discussed the need for awareness about cancer subtypes and their prevalence in certain populations.

Although participants in the study had greater rates of nonadherence postintervention, those who reported nonadherence at baseline saw some increase in adherence.
Real-world data show that older adults with lenalidomide-refractory MM have poor survival outcomes after 1 to 3 lines of therapy.

Clinical response rates were higher in patients with phlebotomy-dependent polycythemia vera who received rusfertide than in those who received placebo.

The FDA has granted PYX-201 fast track designation for treatment of recurrent or metastatic HNSCC after progression post-chemoimmunotherapy.